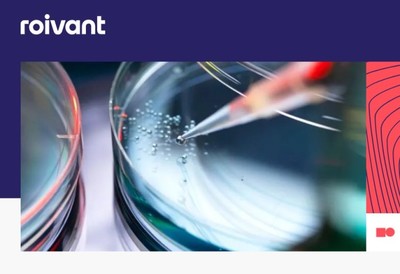

이 기사는 2월 9일 오후 4시43분 '해외 주식 투자의 도우미' GAM(Global Asset Management)에 출고된 프리미엄 기사입니다. GAM에서 회원 가입을 하면 9000여 해외 종목의 프리미엄 기사를 보실 수 있습니다.
<로이반트 신고가 ① 피부 사르코이드증 치료제 '획기적' 성과>에서 이어짐
[서울=뉴스핌] 김현영 기자 = 피부 사르코이드증(CS)은 염증성 육아종성 피부질환으로 미국 내 약 4만 명의 성인에게 영향을 미치지만, 현재까지 승인된 치료제가 없다. 환자들은 장기간 전신 코르티코스테로이드, 면역억제제, 생물학적 제제를 오프라벨로 사용하고 있으나 효과가 제한적이고 부작용 위험이 높은 실정이다.
로이반트 사이언시스(종목코드: ROIV)의 브레포시티닙은 TYK2와 JAK1을 선택적으로 동시에 억제하는 이중 억제제로, 자가면역 관련 주요 사이토카인을 단일 경구제로 효과적으로 억제한다는 점에서 차별화된다.
◆ 파이프라인 전반의 모멘텀 확대
브레포시티닙은 최근 피부근염에서 긍정적인 3상 결과를 도출해 올해 초 신약허가신청(NDA)을 제출했으며, 비감염성 포도막염 3상 임상도 진행 중으로 올해 하반기 주요 결과가 발표될 예정이다. 피부 사르코이드증까지 더해지면 브레포시티닙은 세 가지 주요 적응증에서 후기 임상 단계에 진입하게 된다.
로이반트의 매트 글라인 최고경영자(CEO)은 "2025년은 임상 실행의 질과 데이터에 힘입어 로이반트에 변혁적인 해였다"며 "2026년 후기 단계 파이프라인 전반에서 초기 모멘텀을 확보했으며, 또 한 번 획기적인 해를 만들어갈 야심을 갖고 있다"고 밝혔다.
프로이반트의 벤 짐머 CEO는 "BEACON 연구 결과에 매우 고무돼 있으며, 브레포시티닙을 빠르게 3상 개발 단계로 진입시킬 수 있게 되어 기쁘다"며 "기존 치료 옵션으로 충분히 대응되지 못한 중증 자가면역질환 환자들에게 변혁적 치료제를 개발하려는 목표를 계속 추진해 나갈 것"이라고 강조했다.
브레포시티닙 외에도 로이반트는 더 넓은 파이프라인 전반에 걸친 진행 상황을 강조했다. 치료가 어려운 류마티스 관절염에 대한 IMVT-1402 EXPLORE 3상 연구는 현재 170명의 환자가 완전히 등록됐다. 회사는 IMVT-1402를 유리한 효능, 안전성 프로필, 편리한 투여를 갖춘 동급 최고의 치료제로 자리매김하고 있다.
간질성 폐질환(PH-ILD) 관련 폐고혈압에 대한 모슬리시구앗 PHocus 2상 연구도 환자 등록을 완료했다. 모슬리시구앗은 1일 1회 흡입형 가용성 구아닐산 고리화 효소(sGC) 활성제로, 전신 부작용을 제한하면서 표적 폐 혈관 확장을 제공하도록 설계됐다. 주요 결과는 올해 하반기 발표될 예정이다.
◆ 재무 현황 및 향후 전망
로이반트는 지난 12월 31일 기준 2026 회계연도 3분기 실적도 함께 발표했다. 주당 순이익 -0.38달러(예상치 -0.31달러)와 199만 달러의 매출(예상치 513만 달러)로 분석가 예상치를 하회했다.
3개월간 연구개발 비용은 1억 6540만 달러로 전년 동기 대비 2380만 달러 증가했으며, 일반관리비는 1억 7510만 달러로 3350만 달러 늘었다. 계속 사업 순손실은 3억 1370만 달러로 전년 동기 대비 확대됐으나, 이는 주요 파이프라인 진척에 따른 투자 확대를 반영한 것으로 풀이된다.
그럼에도 로이반트는 2025년 12월 31일 기준 45억 달러의 현금, 현금 등가물, 제한된 현금 및 시장성 증권을 보유하고 있으며 대차대조표에 부채가 없다. 이 상당한 현금 보유고는 여러 적응증에 걸친 회사의 야심찬 임상 개발 계획을 위한 활주로를 제공한다.
시장은 현재 재무 성과보다는 로이반트의 파이프라인 잠재력에 집중하는 것으로 보인다. 회사의 전략은 특히 여러 적응증에 걸쳐 15만 명 이상의 환자를 치료할 준비가 된 브레포시티닙과 같은 주요 자산에 대한 적응증을 확대하는 데 중점을 둔다.
◆ 월가 목표가 잇따라 상향
CNBC 집계에 따르면 현재 12개 투자은행 중 5곳이 '강력 매수', 6곳이 '매수', 1곳만 '보유' 의견을 제시하고 있으며, 평균 목표주가는 28.55달러로 현재 주가 대비 10.57%의 추가 상승 여력을 보여준다. 월가 최고 목표가는 38달러, 최저 목표가는 22달러다.
뱅크오브아메리카(BofA)는 로이반트의 목표주가를 기존 22달러에서 26달러로 상향 조정했다. 애널리스트는 이번 목표주가 상향 조정이 긍정적인 결과에 따른 브레포시티닙 매출 전망치 상향을 반영한 것이라고 설명했다.
제프리스는 목표주가를 24달러에서 30달러로 상향 조정하고 '매수' 의견을 재확인했다. 애널리스트는 "브레포시티닙이 시간이 지남에 따라 적응증이 확대되면서 희귀질환 분야의 린보크가 될 수 있다"는 논리를 제시했다.
구겐하임도 목표주가를 28달러에서 30달러로 상향 조정하고 '매수' 의견을 유지했다.
2014년 비벡 라마스와미에 의해 설립된 로이반트 사이언시스는 영국 런던에 본사를 두고 있으며, 혁신적 의약품 개발을 목표로 하는 바이오의약품 전문기업이다. 회사는 의약품 및 기술 개발·상용화를 위해 민첩한 자회사 '반트(Vants)' 구조를 운영하며 파이프라인을 효율적으로 관리하고 있다.
브레포시티닙의 피부 사르코이드증 임상 성공이 로이반트의 성장 궤도를 한층 강화할 것으로 기대된다.
kimhyun01@newspim.com
 영상
영상